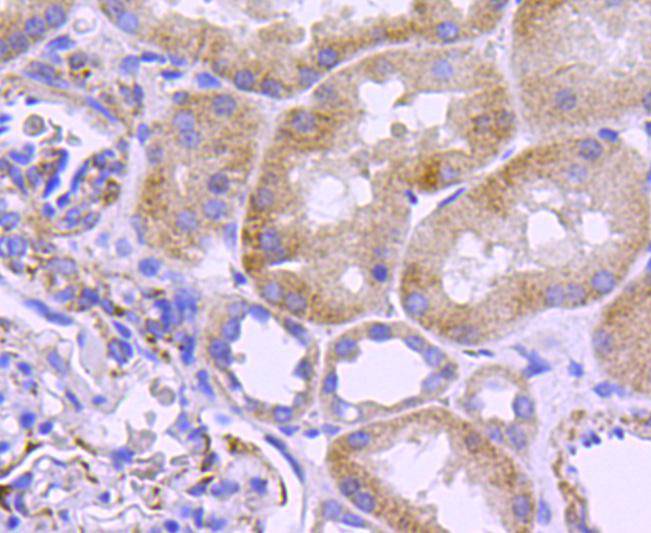
Fig1: Immunohistochemical analysis of paraffin-embedded human kidney tissue using anti-Filamin A antibody. Counter stained with hematoxylin.

-
Product Name
Anti-Nes antibody
- Documents
-
Description
Rabbit polyclonal antibody to Nes
-
Tested applications
IHC-P
-
Species reactivity
Human, Mouse
-
Alternative names
RC antibody; Ifa antibody; Mar antibody; RC2 antibody; ESTM4 antibody; Marc2 antibody; C78523 antibody; ESTM46 antibody; Ifaprc2 antibody; AA166324 antibody
-
Isotype
Rabbit IgG
-
Preparation
This antigen of this antibody was synthetic peptide within human nestin aa 1279-1323.
-
Clonality
Polyclonal
-
Formulation
Liquid, 1*PBS (pH7.4), 0.2% BSA, 40% Glycerol. Preservative: 0.05% Sodium Azide.
-
Storage instructions
Store at +4℃ after thawing. Aliquot store at -20℃ or -80℃. Avoid repeated freeze / thaw cycles.
-
Applications
IHC-P: 1:50-200
-
Validations
Fig1: Immunohistochemical analysis of paraffin-embedded human kidney tissue using anti-Filamin A antibody. Counter stained with hematoxylin.

Fig2: Immunohistochemical analysis of paraffin-embedded mouse brain tissue using anti-Filamin A antibody. Counter stained with hematoxylin.
- Background
-
References
- Hornsby AK et al. Short-term calorie restriction enhances adult hippocampal neurogenesis and remote fear memory in a Ghsr-dependent manner. Psychoneuroendocrinology 63:198-207 (2016).
- Piao Y et al. Novel MET/TIE2/VEGFR2 inhibitor altiratinib inhibits tumor growth and invasiveness in bevacizumab-resistant glioblastoma mouse models. Neuro Oncol 18:1230-41 (2016).
- Fang L et al. Jumonji AT-rich interactive domain 1B overexpression is associated with the development and progression of glioma. Int J Mol Med 38:172-82 (2016).
Related Products / Services
Please note: All products are "FOR RESEARCH USE ONLY AND ARE NOT INTENDED FOR DIAGNOSTIC OR THERAPEUTIC USE"
